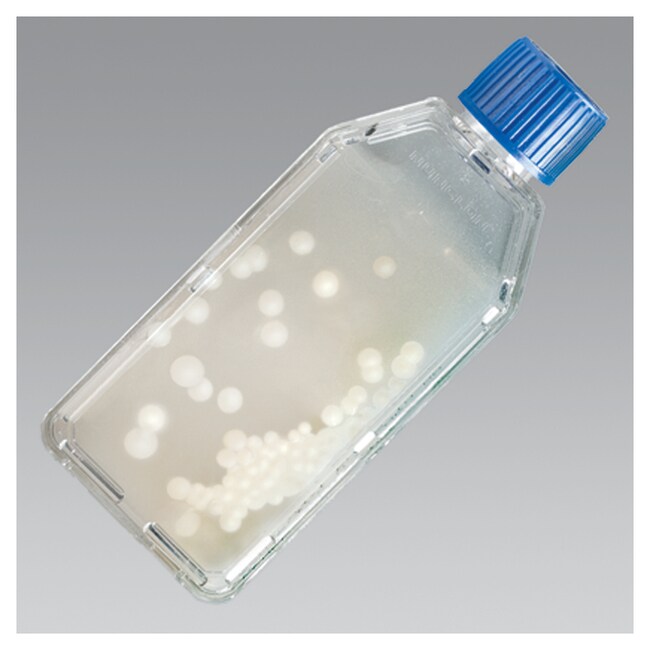
马铃薯薄片琼脂 Bactiflask&trade;

Search

Thermo Scientific™
马铃薯薄片琼脂 Bactiflask™
Thermo Scientific™ Remel 马铃薯薄片琼脂 Bactiflask 用于真菌鉴定。
货号 R10266
价格(CNY)
-
Thermo Scientific™ Remel 马铃薯薄片琼脂 Bactiflask 用于真菌鉴定。
规格
描述马铃薯薄片琼脂 Bactiflask™
产品规格1 oz. TCF
数量20 支/包
产品类型琼脂
Unit SizeEach
Search
Thermo Scientific™ Remel 马铃薯薄片琼脂 Bactiflask 用于真菌鉴定。